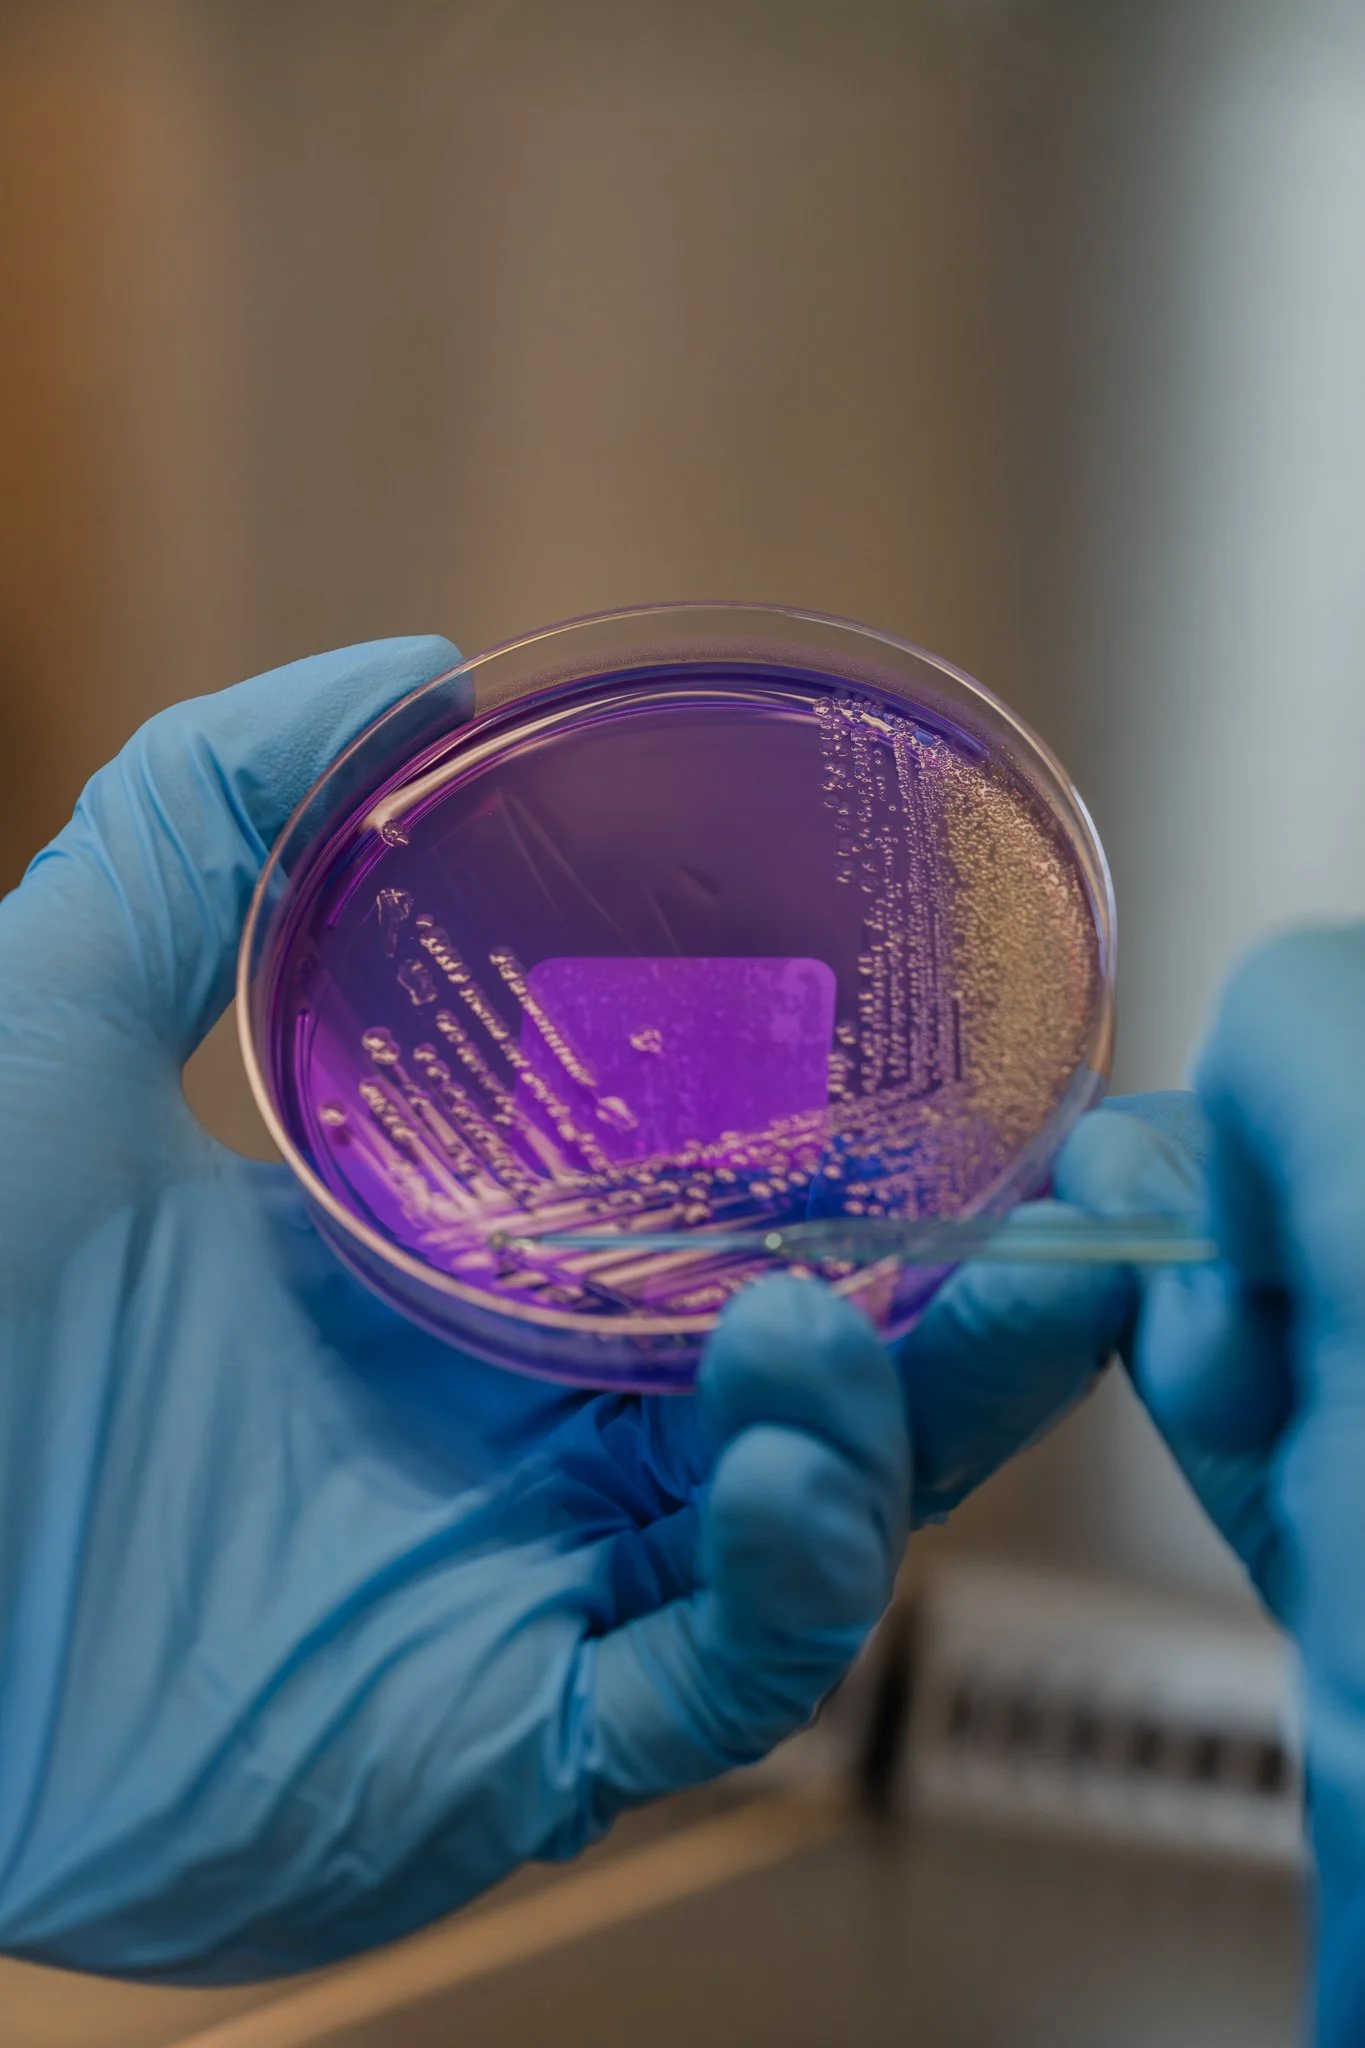
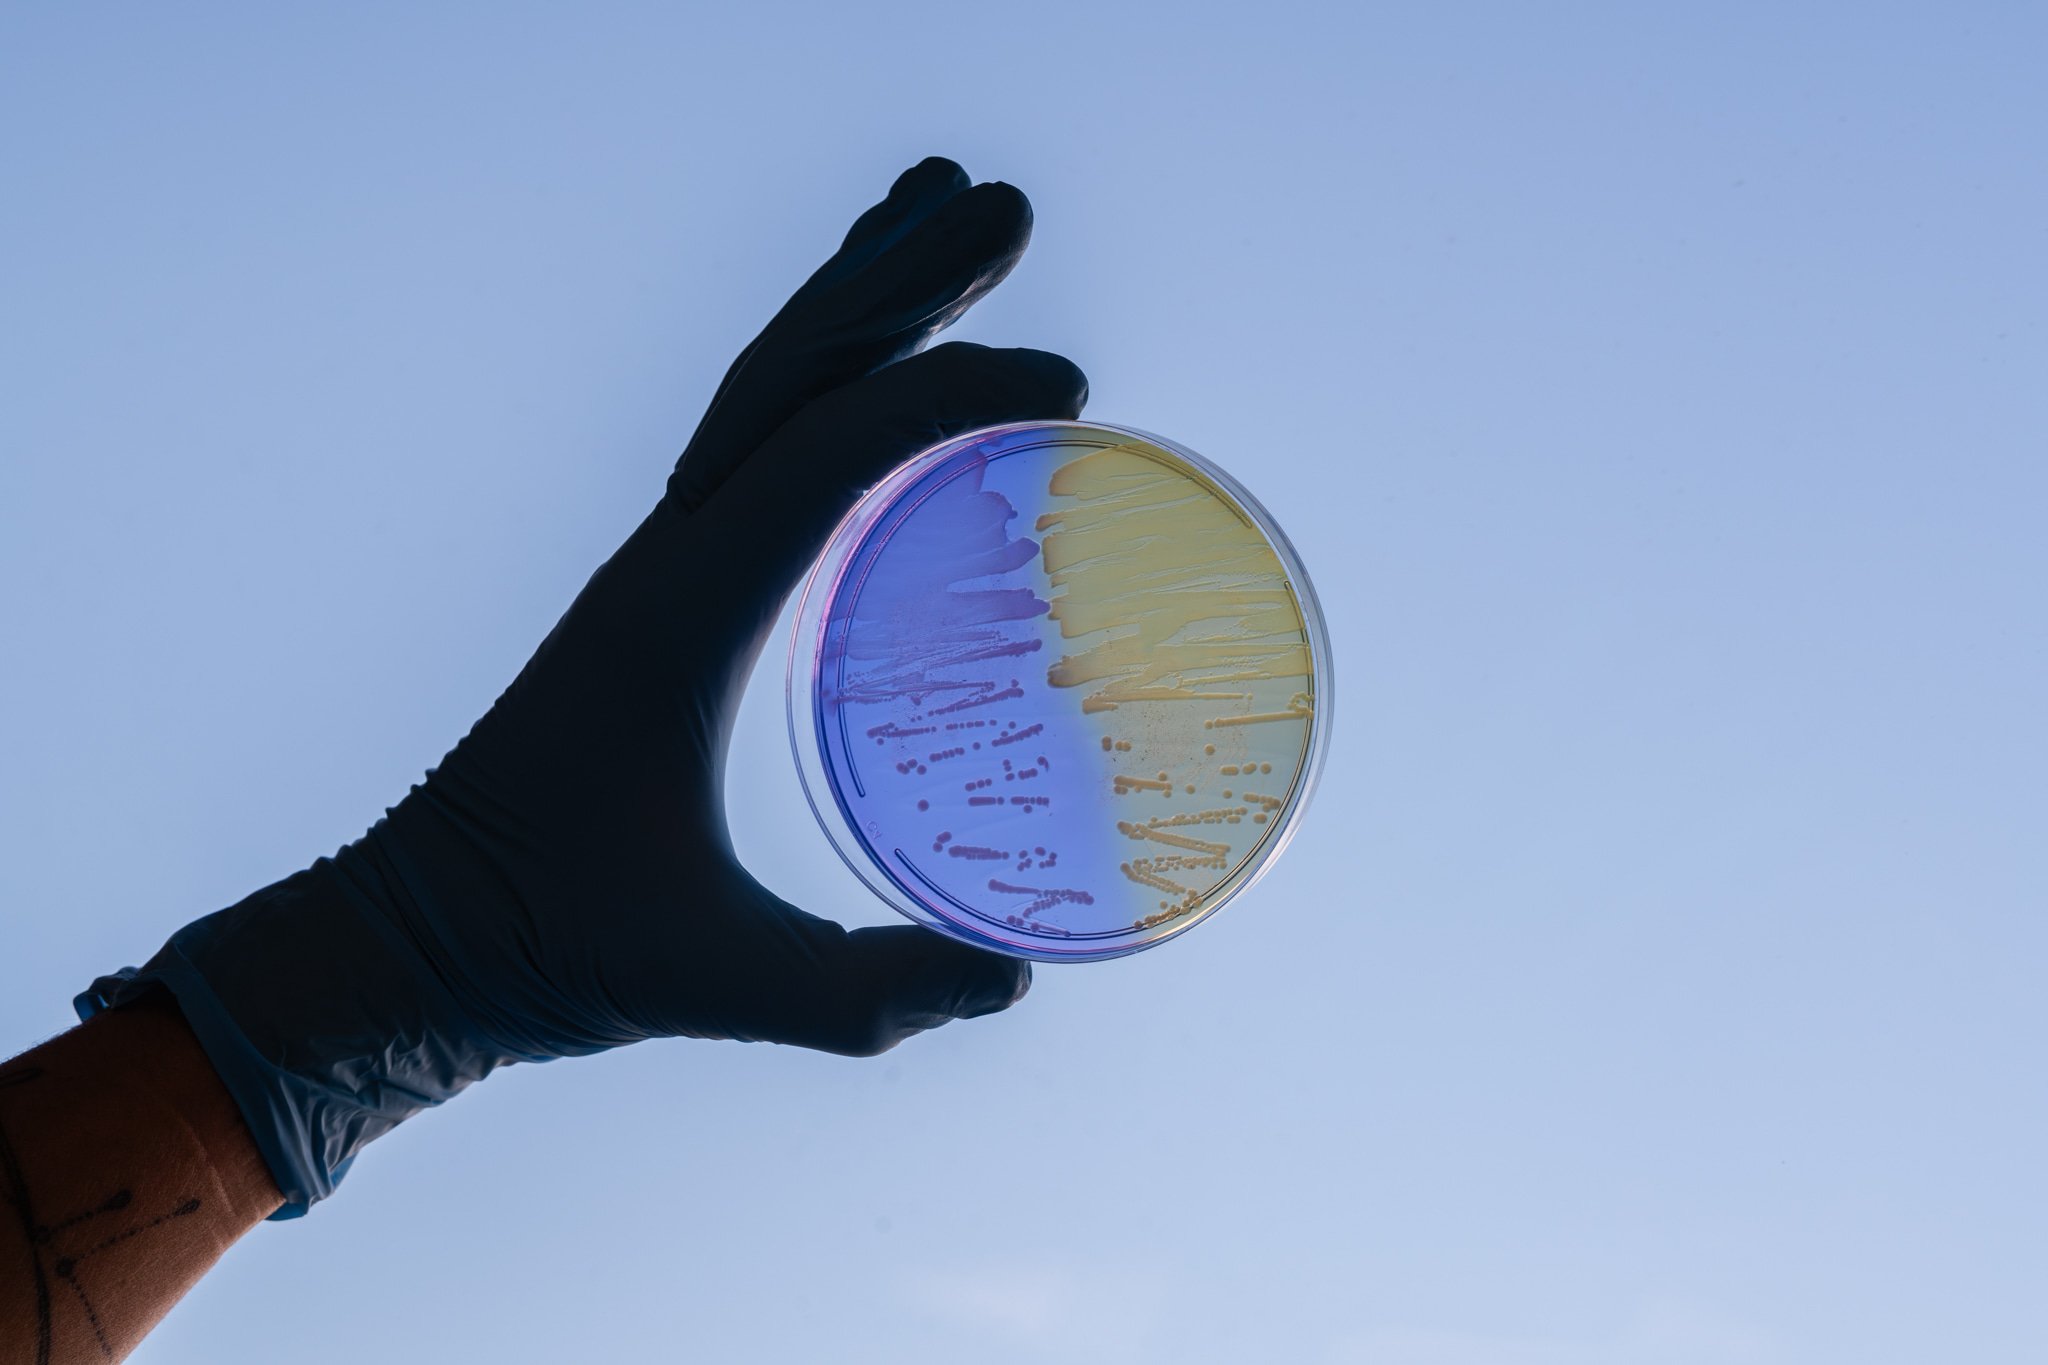

UNIBIO.
Une plongée au cœur de la science et de la précision.
Nous avons réalisé une série de photos artistiques au sein d’un laboratoire d’analyses médicales, pour mettre en lumière l’humain derrière la technique.
Un regard esthétique et authentique sur un univers souvent perçu comme froid — capturant la rigueur, la passion et le savoir-faire qui font battre le cœur d’Unibio.